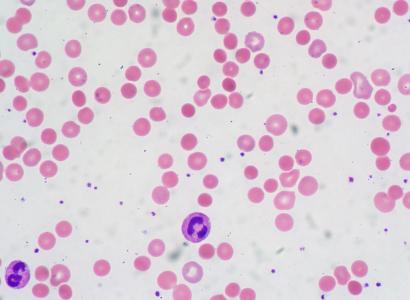

ColumbusFreepress.com is now Freepress.org
The Columbus Institute of Contemporary Journalism (CICJ) has operated Freepress.org since 2000 and ColumbusFreepress.com was started initially as a separate project to highlight the print newspaper and local content.
ColumbusFreepress.com has been operating as a project of the CICJ for many years and so the sites are now being merged so all content on ColumbusFreepress.com now lives on Freepress.org
The Columbus Freepress is a non-profit funded by donations we need your support to help keep local journalism that isn't afraid to speak truth to power alive.
To donate go to our Donate page today.